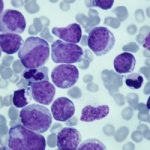
سرکوب مغز استخوان

چگونه ایمونوتراپی می تواند سرطان کلیه را درمان کند؟
ایمونوتراپی از سیستم ایمنی برای حمله به سرطان کلیه استفاده میکند. میتواند پیشرفت بیماری را کند و در برخی موارد تومورها را کوچک کند. انواع مختلفی از ایمونوتراپی وجود دارد که سرطان کلیه را درمان میکند. اغلب، اگر یک درمان مؤثر نباشد، پزشک ممکن است درمان دیگری را توصیه کند. این مقاله بر روی ایمونوتراپی […]